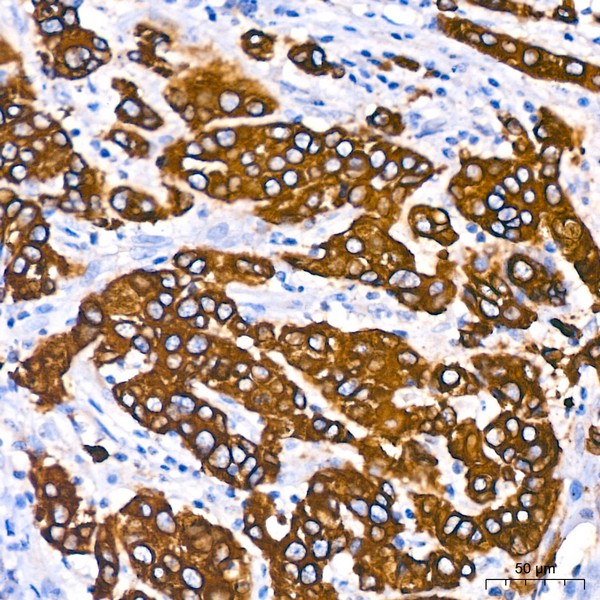
A19778: Cytokeratin 18 (KRT18) Rabbit mAb

Cytokeratin 18 (KRT18) Rabbit mAb (A19778)
$148.00 – $548.00
Abclonal Cytokeratin 18 (KRT18) Rabbit mAb (Catalog Number: A19778) encodes the type I intermediate filament chain keratin 18. Keratin 18, together with its filament partner keratin 8, are perhaps the most commonly found members of the intermediate filament gene family.
- Details & Specifications
- References
| Catalog No. | A19778 |
|---|---|
| Product Name | Cytokeratin 18 (KRT18) Rabbit mAb (A19778) |
| Supplier Name | ABclonal, Inc. |
| Brand Name | Abclonal |
| Synonyms | K18; CK-18; CYK18 |
| Gene Name | KRT18 |
| Protein Name | KRT18 |
| Uniprot/Swissprot ID | P05783 |
| Gene ID | 3875 |
| Clone | ARC2303 |
| Clonality | Monoclonal |
| Source/Host | Rabbit |
| Reactivity | Human, Mouse, Rat |
| Conjugate | Unconjugated |
| Note | Products will be shipped from the warehouse in Massachusetts. Promotion is running from time to time. Welcome to send a request for quote to message@sydlabs.com. |
| Order Offline | Syd Labs, Inc. 4 Avenue E, Hopkinton, MA 01748 USA. Phone: 1-617-401-8149 Fax: 1-617-606-5019 Email: message@sydlabs.com |
Description
A19778: Cytokeratin 18 (KRT18) Rabbit mAb
KRT18 encodes the type I intermediate filament chain keratin 18. Keratin 18, together with its filament partner keratin 8, are perhaps the most commonly found members of the intermediate filament gene family. They are expressed in single layer epithelial tissues of the body. Mutations in this gene have been linked to cryptogenic cirrhosis. Two transcript variants encoding the same protein have been found for this gene.
Immunogen Information about Cytokeratin 18 (KRT18) Rabbit mAb (A19778)
Immunogen:Recombinant fusion protein containing a sequence corresponding to amino acids 250-430 of human Cytokeratin 18 (KRT18) (P05783).
Sequence: ADIRAQYDELARKNREELDKYWSQQIEESTTVVTTQSAEVGAAETTLTELRRTVQSLEIDLDSMRNLKASLENSLREVEARYALQMEQLNGILLHLESELAQTRAEGQRQAQEYEALLNIKVKLEAEIATYRRLLEDGEDFNLGDALDSSNSMQTIQKTTTRRIVDGKVVSETNDTKVLRH
Gene ID:3875
Swiss prot:P05783
Synonyms:K18; CK-18; CYK18; Cytokeratin 18 (KRT18)
Calculated MW:48kDa
Observed MW:48kDa
Images of Cytokeratin 18 (KRT18) Rabbit mAb (A19778)

Western blot analysis of extracts of various cell lines, using Cytokeratin 18 (KRT18) Rabbit mAb (A19778) at 1:1000 dilution.
Secondary antibody: HRP Goat Anti-Rabbit IgG (H+L) (AS014) at 1:10000 dilution.
Lysates/proteins: 25μg per lane.
Blocking buffer: 3% nonfat dry milk in TBST.
Detection: ECL Basic Kit (RM00020).
Exposure time: 1s.

Immunohistochemistry analysis of paraffin-embedded human breast cancer using Cytokeratin 18 (KRT18) Rabbit mAb (A19778) at dilution of 1:800 (40x lens).Perform high pressure antigen retrieval with 10 mM citrate buffer pH 6.0 before commencing with IHC staining protocol.

Immunohistochemistry analysis of paraffin-embedded human colon carcinoma using Cytokeratin 18 (KRT18) Rabbit mAb (A19778) at dilution of 1:800 (40x lens).Perform high pressure antigen retrieval with 10 mM citrate buffer pH 6.0 before commencing with IHC staining protocol.

Immunohistochemistry analysis of paraffin-embedded human colon using Cytokeratin 18 (KRT18) Rabbit mAb (A19778) at dilution of 1:800 (40x lens).Perform high pressure antigen retrieval with 10 mM citrate buffer pH 6.0 before commencing with IHC staining protocol.

Immunohistochemistry analysis of paraffin-embedded human liver using Cytokeratin 18 (KRT18) Rabbit mAb (A19778) at dilution of 1:800 (40x lens).Perform high pressure antigen retrieval with 10 mM citrate buffer pH 6.0 before commencing with IHC staining protocol.

Immunofluorescence analysis of Human mammary cancer using Cytokeratin 18 (KRT18) antibody (A19778) at dilution of 1:100. Blue: DAPI for nuclear staining.

Immunofluorescence analysis of Mouse colon using Cytokeratin 18 (KRT18) antibody (A19778) at dilution of 1:100. Blue: DAPI for nuclear staining.

Immunofluorescence analysis of Rat rectum using Cytokeratin 18 (KRT18) antibody (A19778) at dilution of 1:100. Blue: DAPI for nuclear staining.
Please remember our product information: Cytokeratin 18 (KRT18) Rabbit mAb (Catalog Number: A19778) Abclonal